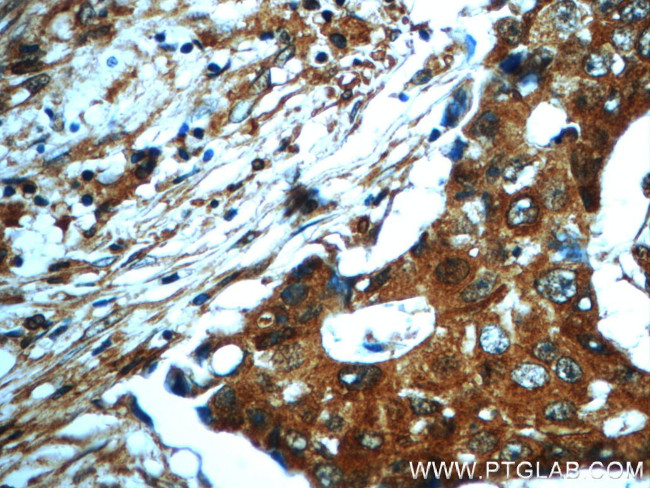
PAWR Antibody in Immunohistochemistry (Paraffin) (IHC (P))

Search
Proteintech
PAWR Polyclonal Antibody
{{$productOrderCtrl.translations['antibody.pdp.commerceCard.promotion.promotions']}}
{{$productOrderCtrl.translations['antibody.pdp.commerceCard.promotion.viewpromo']}}
{{$productOrderCtrl.translations['antibody.pdp.commerceCard.promotion.promocode']}}: {{promo.promoCode}} {{promo.promoTitle}} {{promo.promoDescription}}. {{$productOrderCtrl.translations['antibody.pdp.commerceCard.promotion.learnmore']}}








Please note: We are reviewing Western blot images included in the antibody testing data in our catalog, including those provided by third parties. Unless expressly labeled or annotated as “raw-unedited”, Western blot images included in the antibody testing data in our catalog may have been edited, optimized or otherwise adjusted for presentation.
产品信息
20688-1-AP
种属反应
宿主/亚型
分类
类型
抗原
偶联物
形式
浓度
规格
纯化类型
保存液
内含物
保存条件
运输条件
产品详细信息
The antibody is specific to PAWR.
靶标信息
This gene encodes a tumor suppressor protein that selectively induces apoptosis in cancer cells through intracellular and extracellular mechanisms. The intracellular mechanism involves the inhibition of pro-survival pathways and the activation of Fas-mediated apoptosis, while the extracellular mechanism involves the binding of a secreted form of this protein to glucose regulated protein 78 (GRP78) on the cell surface, which leads to activation of the extrinsic apoptotic pathway. This gene is located on the unstable human chromosomal 12q21 region and is often deleted or mutated different tumors. The encoded protein also plays an important role in the progression of age-related diseases.
仅用于科研。不用于诊断过程。未经明确授权不得转售。
生物信息学
蛋白别名: Par-4; par-4 induced by effectors of apoptosis; PRKC apoptosis WT1 regulator protein; prostate apoptosis response 4; Prostate apoptosis response 4 protein; Prostate apoptosis response protein 4; Transcriptional repressor Par-4-like protein PAWR
基因别名: 2310001G03Rik; Par-4; PAR4; PAWR
UniProt ID: (Rat) Q62627, (Mouse) Q925B0
Entrez Gene ID: (Rat) 64513, (Mouse) 114774